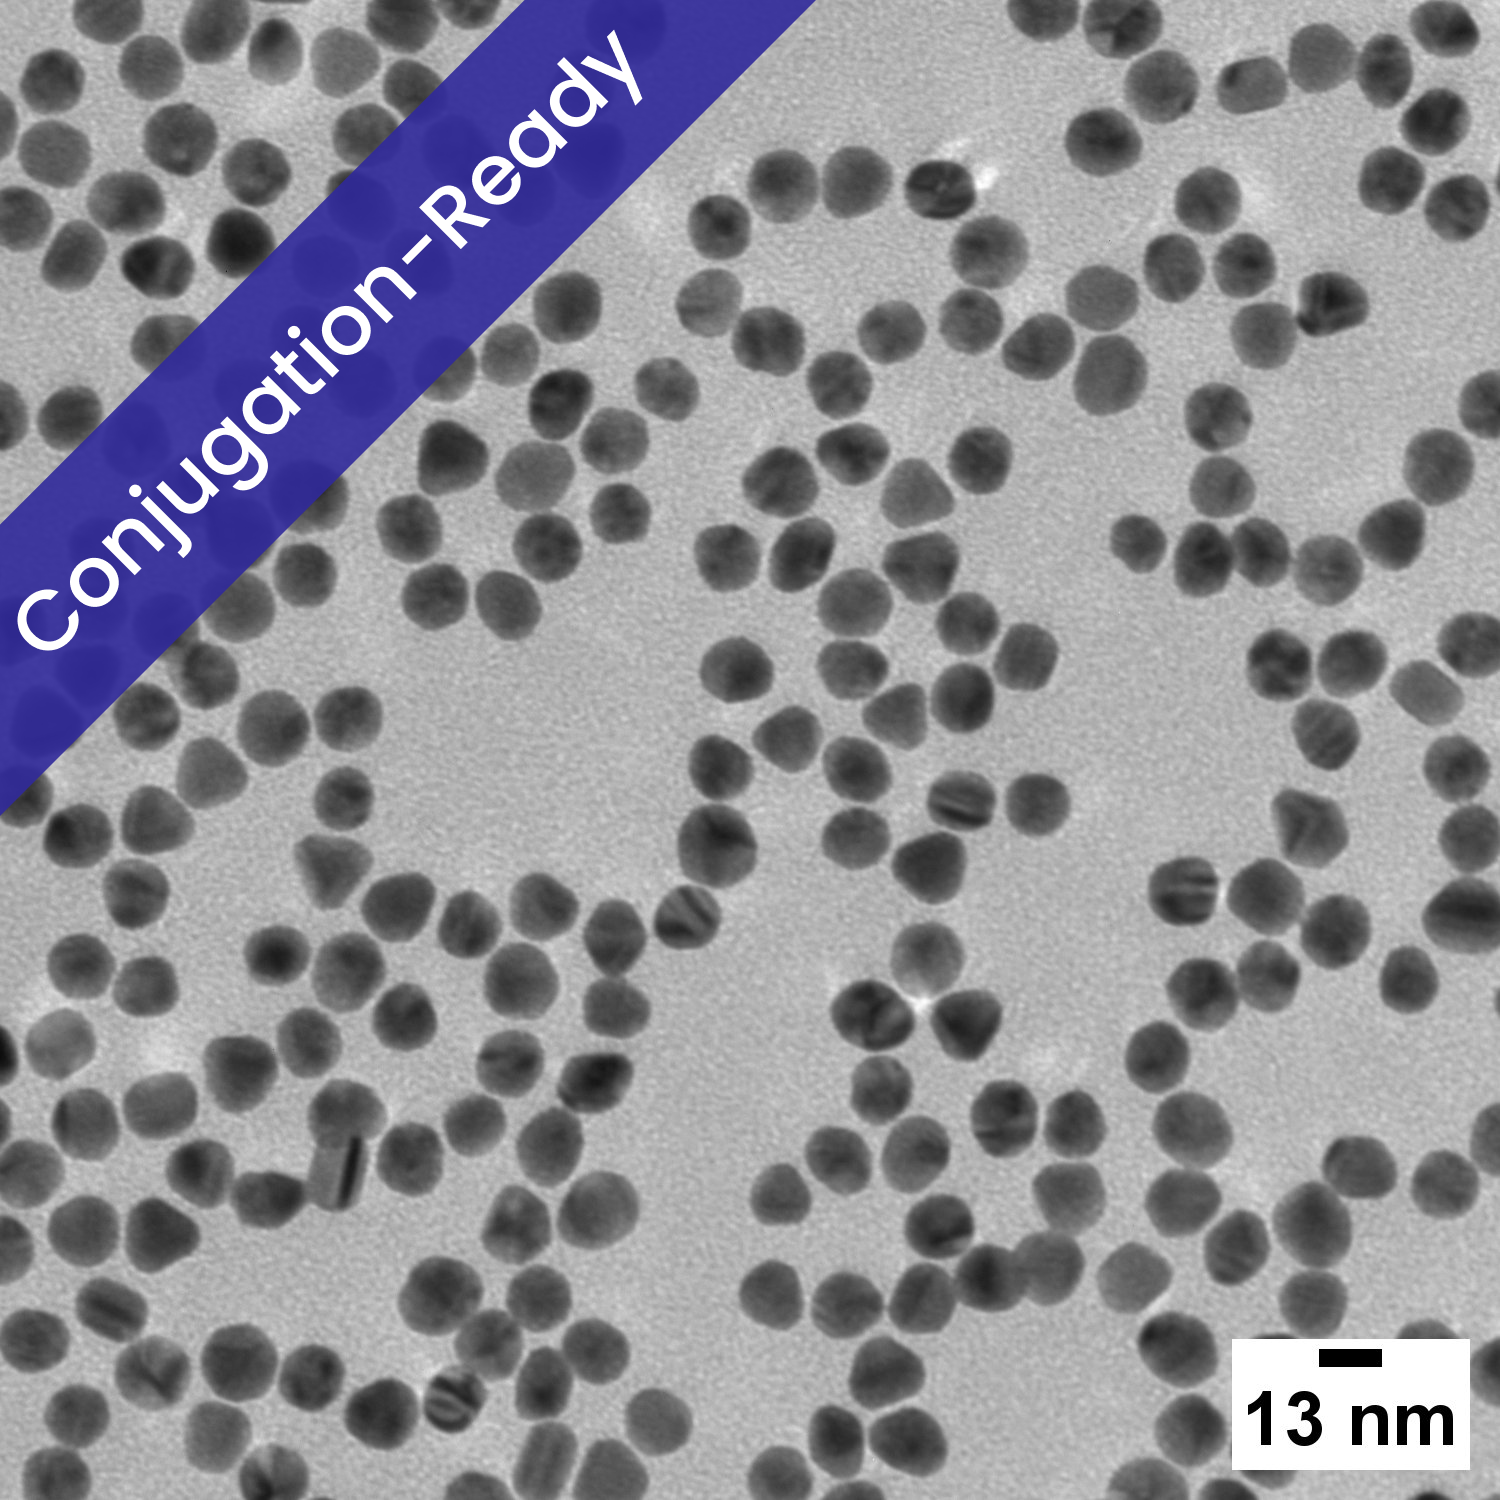

13 nm Gold Nanospheres for Conjugation
Regular price
$100.00 USD
Customers outside of the US & Canada: please visit your local distributor’s website to purchase this item using its SKU, or contact us here. Thank you!
In-stock items are expected to ship within 5 days of order acceptance.
13 nm spherical gold nanoparticles for conjugation are useful in applications such as spherical nucleic acid therapeutics and diagnostics.
nanoComposix provides high quality, monodisperse, and aggregation-free nanomaterials. All our products are supplied with a batch-specific Certificate of Analysis including characterization data such as TEM, DLS, Zeta, and UV-Vis.
Intended For Research Use Only. Not for use in diagnostic procedures. Contact us for custom formulations, ISO 13485/cGMP compliant materials, or bulk supply requirements.
| Overview | |
|---|---|
| Surface | Citrate |
| Description | For passive adsorption |
| Solvent | 0.02 mM sodium citrate |
| Surface chemistry | Citrate |
| Specifications | |
| TEM Diameter | 13 ± 3 nm |
| CV | ≤ 15% |
| Documents | |
| Example Certificate of Analysis (CoA) | Download |
| Safety Data Sheet (SDS) | 1 OD (AUCLR13) |
| Storage & Handling | Download |
| Protocols | Antibody Purification Passive Adsorption Tutorial Video ↗ |
| Expected Ranges | |
| Hydrodynamic diameter (DLS) | TEM diameter + 0-15 nm |
| Zeta potential | ≤ –15 mV |
| pH of solution | 5.5–8.5 |
| Peak wavelength (λmax) | 515–520 nm |